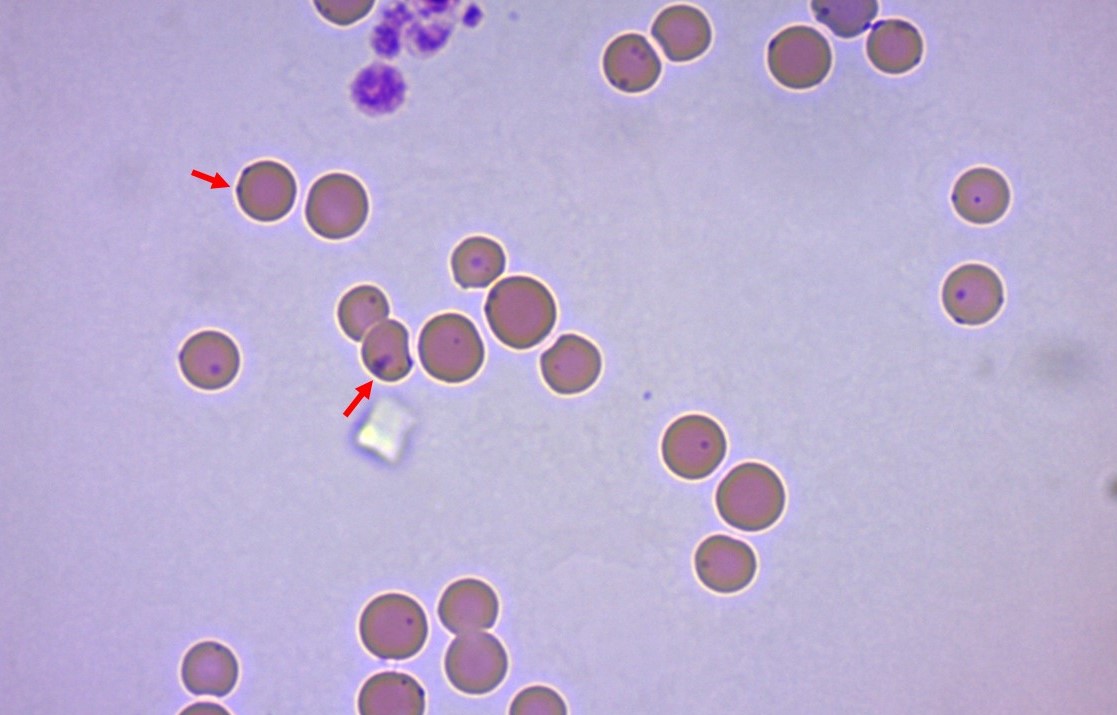

犬や猫の献血にご協力ください ~安全な献血を行うための当院の取り組みをご紹介します~
皆様は献血をされたことはありますか?
自分の健康状態や血液が献血に適しているのか、その場で医師の診察や検査を行うことで安心して献血を受けることができています。
あまり知られていませんが、実は犬や猫にも献血があります。当院では動物に負担の少ない安全な献血を行っており、たくさんの輸血が必要な動物を救うお手伝いをしてもらっています。

大森(愛玩動物看護師)
日々育児と仕事を両立するため健康管理に気を付けている。趣味はサイクリングや登山と休日もアクティブに活動。「正確な仕事は美しい環境から」をモットーに院内の環境整備やマネジメントに関して精力的に動く日々。院内のムードメーカーとしていつもみんなの笑顔の中心にいる。
献血時の検査
献血ドナーとして希望された犬や猫には全身的に検査を行い、健康状態に問題がないことを確認してから登録を行っています。
一番私たちが重視していることが献血ドナーとして登録していただく犬や猫に安全な献血を行うことです。
献血を行う前に、登録時には全身の血液検査、血液化学検査、尿検査、血液型検査、感染症検査を実施しています。
献血は年に2回まで実施が可能で、2回目の献血時には簡易的な検査のみの実施となります。

血液検査(血球検査)
血液中の赤血球や白血球、血小板の数や大きさを測定し、体の中で炎症がないか、貧血や脱水がないか、止血能力に異常がないかを見ていきます。
赤血球数やヘマトクリット値、ヘモグロビン値に異常がある場合は高値の場合は血が濃い程度なので問題がないことが多いですが、低い場合は貧血の可能性があるため献血は行えません。
献血が実施できる基準を設定し、それを守って献血を行います。赤血球は体内の酸素や二酸化炭素などを運ぶ役割があります。
白血球数は体内の炎症などを評価しています。顕著な高値がある場合は何かの疾患が隠れている可能性があるため炎症の発生場所などを探索します。
血小板は絆創膏のように傷にふたをすることで止血する役割を担います。血小板が少ない場合は止血に問題がある可能性があるので、献血は行いません。
血液化学検査
血液化学検査では各臓器に異常がないかを確認します。
肝臓や腎臓、膵臓に関連した数値や血糖値、タンパク質、コレステロールやミネラルなどの栄養系の数値を測定します。犬では17項目、猫では15項目を測定します。
基準値から外れている場合、項目に該当する臓器での異常が認められることがありますので再検査や精査が必要となります。検査前に食事をとった場合など数値が変動することがありますので、必ず絶食状態で受けていただきます。
尿検査
尿の成分は体にとって不要なものが主となりますが、腎臓や膀胱、尿道の異常によっては必要な成分が一緒に流れ出てしまうことがあります。数値に異常が出た場合には腎臓、膀胱や尿道の働きや構造に異常がないか調べます。
血液型検査
人ではABO型分類とRH型分類の2種類ありますが、犬ではDEA1.1型分類、猫ではAB型分類があり輸血時に重要なポイントとなります。詳しくはこちらで解説しています。
関連記事
あなたのわんちゃん猫ちゃんの血液型、知ってますか?
献血によっていただいた血液は輸血を必要としている犬や猫に提供します。
その際、血液型が異なると免疫反応により拒否反応(輸血副反応)が出ることがあり、拒否反応が強く出た場合には重症化することもあるため、未然に防ぐために血液型の検査を行います。

感染症検査
地域によって感染しやすい病気は異なりますが、当院では犬はフィラリア症とバベシア症検査を実施しています。
犬の感染症には他にも犬ブルセラ病、犬ヘモプラズマ症、犬エールリヒア症、犬へパトゾーン症、犬ライム病、SFTSなどがありますが、地域によって必要な検査は異なりますので献血を希望する病院でしっかりと説明を受けましょう。
同じように猫では猫免疫不全ウイルス感染症、猫白血病ウイルス感染症、猫ヘモプラズマ感染症、猫コロナウイルスの検査を実施します。
血液を媒介にして感染する感染症を検査することで、輸血によって他の動物に感染するリスクを減らし、また献血に協力してくれるドナー動物の健康管理を行います。
これらの感染症は感染をしていても症状を表さない(不顕性感染)こともあるため、注意が必要です。
ヘモプラズマに感染した猫の赤血球。紫色の粒状のものがヘモプラズマ。
まとめ|安全な献血を行うためには?

当院では献血ドナーとしてご協力していただける犬や猫の健康管理に最大限の注意を払い、安全な献血を実施しております。
こちらの記事を読んでいただき、少しでも献血に興味が出ましたらご協力いただけると嬉しいです。
当院に限らず日本全国に命の輪をつなげていきましょう!